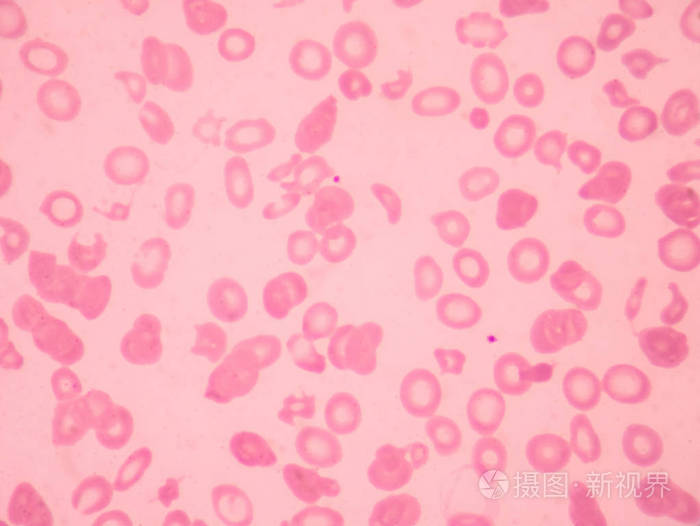
地中海贫血血涂片异常红细胞形态.医学科学概念

异常红细胞

清晰图解红细胞异常及相关疾病
图片尺寸563x744
这些红细胞异常,都掌握了吗?
图片尺寸504x335
清晰图解红细胞异常及相关疾病
图片尺寸564x695
各种异常红细胞
图片尺寸320x249
10.29日学习打卡 #血涂片中的红细胞异常 #学习打卡#血 - 抖音
图片尺寸979x1185
异常红细胞
图片尺寸504x331
20220605-270异常红细胞形态
图片尺寸1080x1439
如图所示的异常红细胞增多可见于
图片尺寸291x272
图所示红细胞属哪一种形态异常
图片尺寸279x268
【临床基本功】红细胞异常知多少4
图片尺寸500x313
异常红细胞星形医学背景.
图片尺寸1128x1100
检验主管技师辅导红细胞形态异常1
图片尺寸497x373
主管检验技师辅导红细胞形态异常
图片尺寸378x284
如图所示的异常红细胞增多可见于()
图片尺寸287x269
检验主管技师辅导红细胞中出现异常结构1
图片尺寸460x345
这些红细胞异常,您都掌握了吗?
图片尺寸327x205
这些红细胞异常,都掌握了吗?
图片尺寸421x310
地中海贫血血涂片异常红细胞形态.医学科学概念
图片尺寸700x526
红细胞形态异常一
图片尺寸421x319
棘细胞,有刺状突起的异常红细胞
图片尺寸1200x800